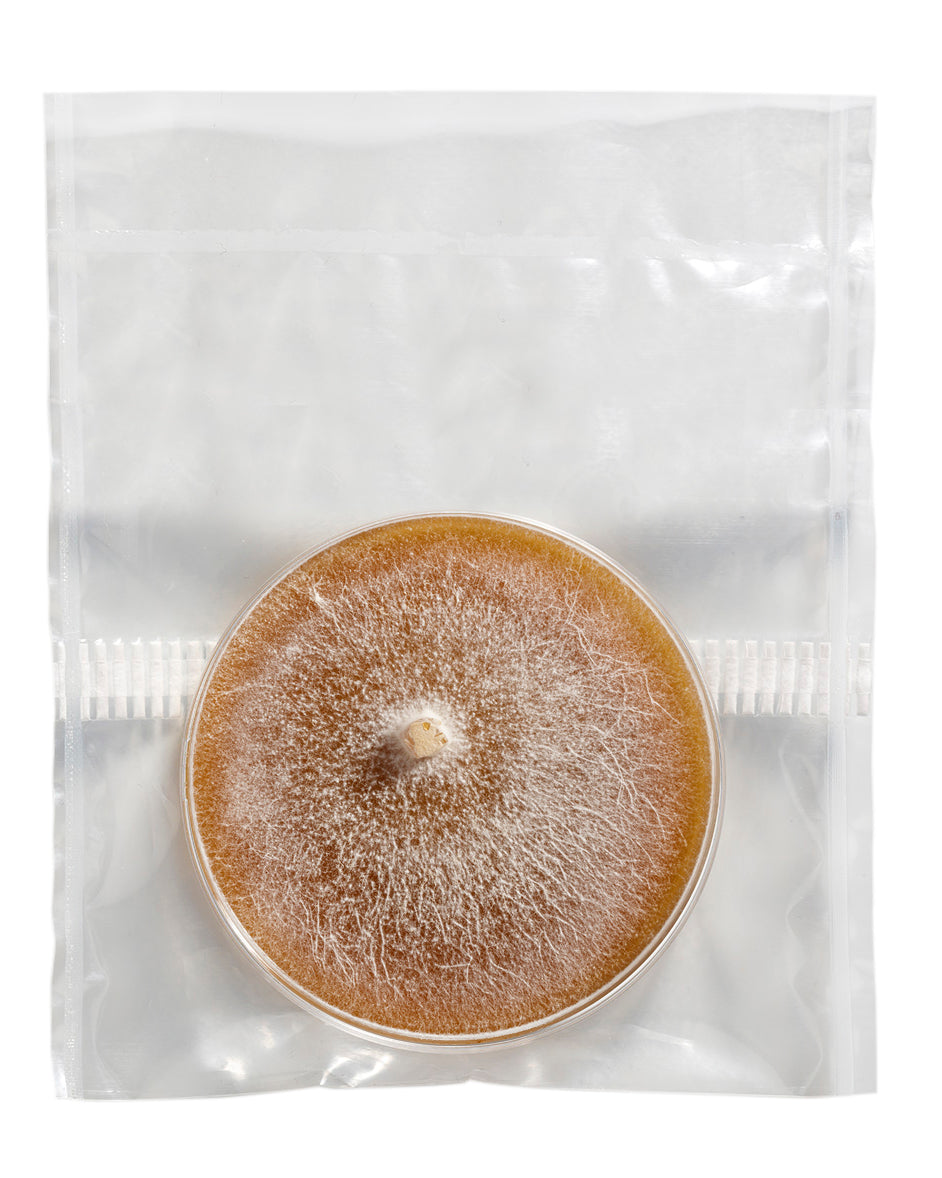
Zipper Filter Bag for Petri Dishes

If you have any questions, you are always welcome to contact us. We'll get back to you as soon as possible, within 24 hours on weekdays.
-
Shipping Information
Use this text to answer questions in as much detail as possible for your customers.
-
Customer Support
Use this text to answer questions in as much detail as possible for your customers.
-
FAQ’s
Use this text to answer questions in as much detail as possible for your customers.
-
Contact Us
Use this text to answer questions in as much detail as possible for your customers.
Product description
Polypropylene Zipper Filter Bag - R Type Filter Bags for Petri Dish. SKU: PPD60/REH1+0/X12*14.